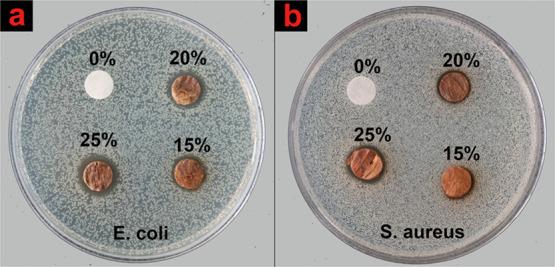
https://cdn.ncbi.nlm.nih.gov/pmc/blobs/c4aa/8908533/7b20427dab60/ao1c06463_0009.jpg

离心纺丝淀粉/聚乙烯醇(ST/PVA)复合超细纤维的交联及负载银纳米颗粒的抗菌活性
Cross-Linking of Centrifugally Spun Starch/Polyvinyl Alcohol (ST/PVA) Composite Ultrafine Fibers and Antibacterial Activity Loaded with Ag Nanoparticles.
作者信息
Li Xianglong, Zhang Yongna, Kong Weicai, Zhou Jing, Hou Teng, Zhang Xianggui, Zhou Lele, Sun Mingbo, Liu Shu, Yang Bin
机构信息
College of Textile Science and Engineering (International Institute of Silk), Zhejiang Sci-Tech University, Hangzhou, Zhejiang 310018, China.
出版信息
ACS Omega. 2022 Feb 22;7(9):7706-7714. doi: 10.1021/acsomega.1c06463. eCollection 2022 Mar 8.
In this research, centrifugally spun ultrafine composite starch/polyvinyl alcohol (ST/PVA) fibers with high water stability were prepared by cross-linking with a mixture of glutaraldehyde and formic acid in the form of vapor phase. The effect of cross-linking temperature combined with time on the water stability, crystal structure, and thermal properties of fibers was investigated to obtain the optimum parameters. On this basis, we further prepared Ag-loaded ST/PVA fibers with different contents of nano silver. The structure and properties of Ag-loaded fibers, which cross-linked under the optimum parameters, were analyzed. As a result, the Ag-loaded fibers exhibited excellent water stability and mechanical properties and possessed inhibition zone diameters of 3 and 2 mm to and , respectively. The antibacterial property of the Ag-loaded ST/PVA fibers provided a new route for developing less costly antibacterial fiber materials in the future.
在本研究中,通过与戊二醛和甲酸的混合蒸汽进行交联,制备了具有高水稳定性的离心纺超细复合淀粉/聚乙烯醇(ST/PVA)纤维。研究了交联温度和时间对纤维水稳定性、晶体结构和热性能的影响,以获得最佳参数。在此基础上,进一步制备了不同纳米银含量的载银ST/PVA纤维。分析了在最佳参数下交联的载银纤维的结构和性能。结果表明,载银纤维表现出优异的水稳定性和机械性能,对大肠杆菌和金黄色葡萄球菌的抑菌圈直径分别为3毫米和2毫米。载银ST/PVA纤维的抗菌性能为未来开发成本较低的抗菌纤维材料提供了一条新途径。